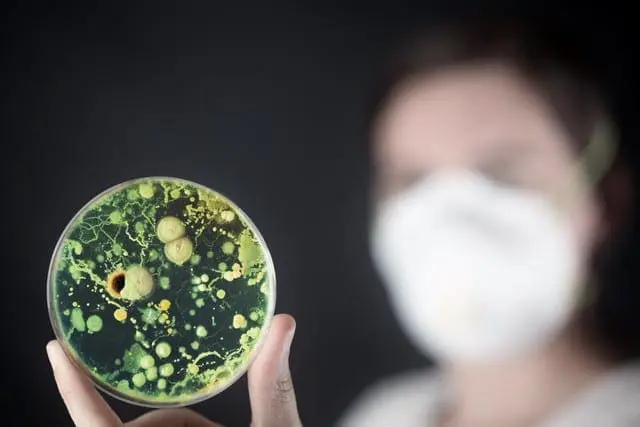
Prevent Mold and Bacteria Growth!

Top 9 Reasons To Hire Flood Response To Clean Your Water Damaged Home or Business!

One of the services that Flood Response specializes in is water damage restoration. We offer this service because the biggest concern that you should have if your home floods or a washing machine hose bursts or one of the pipes burst is mold prevention. Keep in mind, mold will begin growing within 24 to 48 hours, so it is very important that the moisture in your home or business is controlled.
Unfortunately, when people suffer water damage to their properties, they tend to think they can manage the concern themselves using a shop vac and bleach to disinfect.
The temptation to do the job yourself is strong because of the perceived cost savings. However, as this article explains, there are nine critical reasons you should call a professional to manage the water damage concern in your home or business. It is not just about saving a few bucks but ensuring that the moisture problems are properly dealt with to avoid future mold concerns.
If you have a water damage emergency call Flood Response. We are water damage and flood damage restoration experts serving residential and business owners in Palm Springs and many other surrounding areas! For peace of mind, one call does it all, (760) 343-3933!
#1 Even If It Looks Dry, There Still May Be Moisture!
Water always takes the path of least resistance, flowing to the lowest point on your property. Even so, you can’t always know where moisture will hide. Cracks and crevices, cavities in walls and above ceilings, layers of flooring, and all other sorts of places hide water. However, without proper training, without meters to measure the moisture or infra-red cameras, you won’t be able to find all the places water lingers.
This is just another reason to hire Flood Response to get your home or business dried professionally because we locate all the hidden water damage – before it becomes a health threat.
#2 Water Is Heavy!

One gallon of clean water weighs 8.34 pounds.
In a flood damage situation, the hundreds of gallons of water invading your property likely contains contaminants. That makes it even heavier. Once you’ve filled your shop vac with 3-5 gallons of dirty water, you have to get rid of it.
Now imagine lifting and carrying that water-filled bucket weighing 25 to 42 pounds up your basement stairs. Repeatedly!
Don’t risk a back injury just to save a buck, call a professional who has specialized equipment that can remove the water at a much faster speed so that commercial drying equipment and dehumidifiers can be deployed to dry out and remove as much moisture as possible. Again, the major concern of Flood Response is to prevent the onset of mold.
#3 We Want To Save Your Possessions!
Materials and furniture exposed to flood water must be carefully evaluated. If you try to do this on your own, you may discard things that could be saved. Conversely, you may save things that absolutely must be discarded. Part of any professional water damage restoration process is evaluating your possessions. And we explain what’s safe to keep and what you need to discard.
And, for the contaminated items being disposed, we haul it away for you as part of the restoration service!
#4 Flood Water Is Contaminated!

Over the ground flooding from storms carries with it a number of biological contaminants.
Don’t expose yourself to biological contaminants, call a professional that uses proper personal protective equipment.
Keep in mind, even if the water damage did not come from outside, clean water can still contain contaminants if it filtered through building materials.
The only way to determine how many contaminants are in the water is to take a sample and send it to the lab.
#5 We Maximize Your Claim!
We separate damaged items into categories of non-salvageable, salvageable, and questionable items. And, if need be, we pack-out and store your precious belongings for you to clean off-site until the water damage restoration is complete. Because we follow the best practices for water damage restoration, we keep costs down and salvage as much as possible.
#6 Flood Response Are Trained Experts!
For most people, flood or water damage is a once-in-a-lifetime event.
Because of that, we know how devastating it is to see your office disrupted or your family’s possessions soaked and scattered.
We know how to make a difficult time easier for you. Our professional moisture removal methods work. We can replace do-it-yourself guesswork with our proven experience of years in the business.
#7 Prevent Mold and Bacteria Growth!
The biggest health threat after water damage is mold and bacterial growth.
While your home or business will eventually dry out, moisture left inside the walls or under floors starts to grow mold in as little as 24 hours. And mold can damage your family’s or employee’s health for a very long time.
Mold exposure has been linked to:
- Chronic Fatigue Syndrome
- Asthma
- Sinus Infections
- Parkinson’s Disease
- Multiple Sclerosis
- Depression
So don’t chance it! Prevent mold and bacterial growth in your home or business with professional drying.
#8 We Work With Your Insurance Provider!
We use the latest water damage restoration estimating technology. That means we understand their language, and communicate with them to help resolve your insurance claim fast. If you’re a “do it your selfer,” this might be the best reason to get your property dried professionally.
When water damages homes and businesses, whether it’s from storm damage, over the ground floods, or leaking pipes, the time to act is now!
#9 Flood Response Uses Specialized Drying Equipment!
There’s nothing that you can rent from your local hardware store or borrow from your friend down the street that dries out your home or business like the equipment we have.
In a water damage emergency, you need industrial strength fans and dehumidifiers, placed in a very specific pattern for the most efficient drying environment.
Choosing A Water Damage Restoration Company!

- Look for industry experience and leadership.
- Evaluate their reputation of professionalism and customer service. Ask for referrals!
- Check to make sure you hire a company with certified technicians that have knowledge, training and experience to get your property dry fast.
Hiring Flood Response is the best thing you can do for your home and your family following a flood!
Got Water Damage Questions?

Have questions? Ready to hire a professional to help with your water damage repair? Contact us today to learn how we can fix up your water damage and get your home or business looking like new again.
Peace of mind is just a phone call away!
Contact